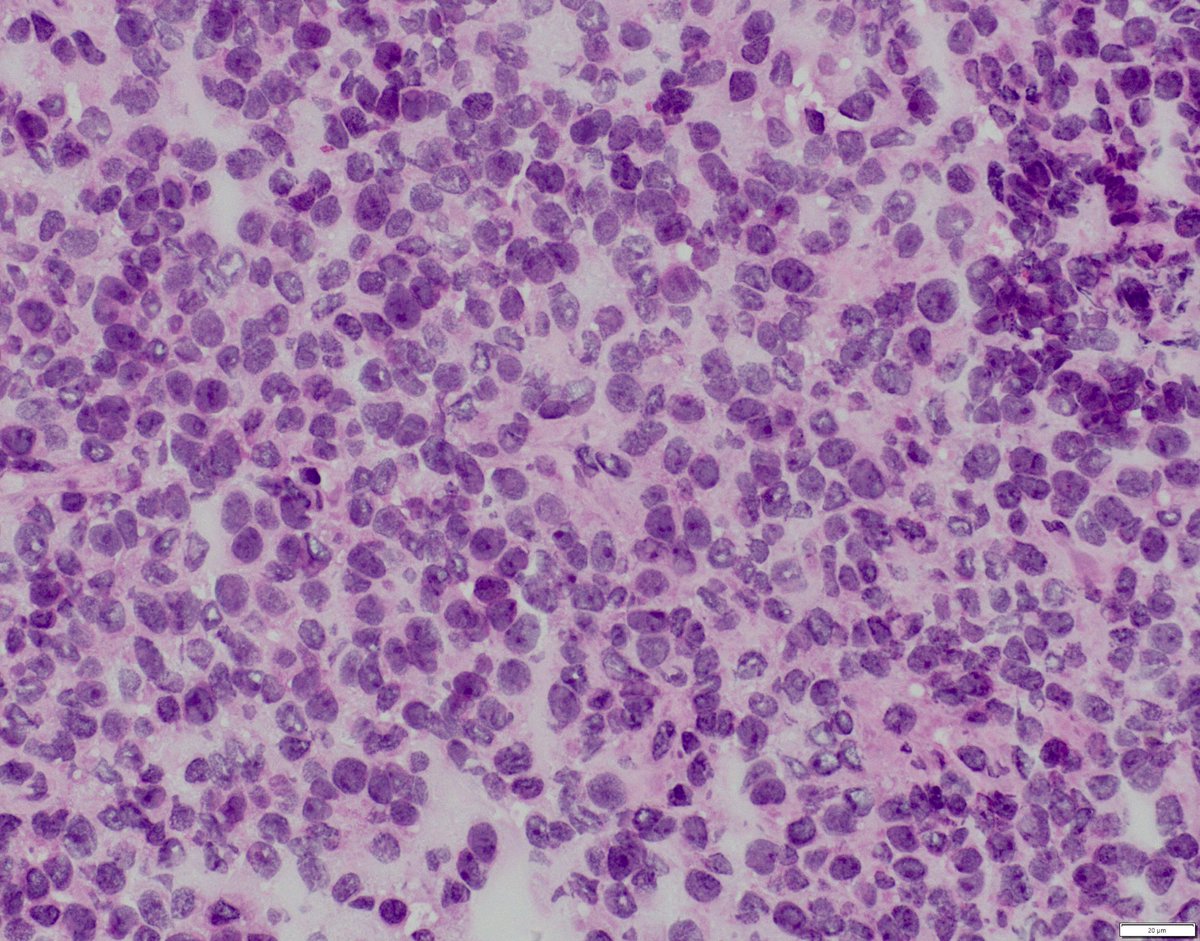
bitar_mireille's tweet image. “Small round blue cell tumor “ in a thigh mass; positive for CD99 and NKX2.2 IHCs, what molecular testing can further support the diagnosis🤔

#bstpath #pedipath #surgpath #molecpath #cytogenetics #pathtwitter

oula fh
@path4ever
Mom for 3 nice boys and histopathologist and interested in head and neck pathology
You might like
Case of Atypical Ductal Hyperplasia (ADH) in Mucocele-Like Lesion 🍪🔬 ☑️ Dilated ducts with extravasated mucin ☑️ Foci of ADH lining mucin-filled spaces ☑️ Upgrade rate to DCIS/invasive carcinoma is 20-40% #PathX #PathTwitter #breastpath

Lichen simplex chronicus 🔬 ✔️Chronic dermatitis characterized by localized areas of thickened skin resulting from chronic scratching ✔️Orthokeratosis with focal parakeratosis ✔️Hypergranulosis ✔️irregular acanthosis ✔️Papillary dermal fibrosis #dermpath #Xpath

Not something you see everyday 👇🏼🧐 Male patient presenting with an anal mass. 🔬What would be your diagnosis? "Leaf" all things aside and check out this case report @ IJSP for the ✅answer: doi.org/10.1177/106689… #PathTwitter #GIPath

One slide one field. Diagnosis? The site is lateral end of clavicle left side

Glycogenated intermediate cells on #papsmear or “Navicular cells” 🛶 🍯💙They contain golden yellow glycogen in the cytoplasm 🤰👩🏽🦳They are abundant in the post-ovulatory phase,during pregnancy and in some menopausal smears #cytopath #cytology #beautyandbenign #simple #worth

‘Fluidity and discontinuity are central to the reality in which we live in’ 60s/F Breast mass Thoughts 💭 #PathTwitter #breastpath #oncopath #PathX

#pathclassic #pathresidents #pathology #gynpath Hyaline globules in ovarian tumors (post-NACT serous carcinoma) Other tumors showing them include hepatocellular carcinoma, Kaposi sarcoma, lung adenoca. Benign/ non-neoplastic inc meningioma,inclusion body fibromatosis, pl adenoma




As we celebrate the 2-year anniversary of the #PathologyPortal, do join us and explore! Discover whole slide images and long cases, to specialist pathology content not available anywhere else! Sign up now to help improve your professional practice: rcpath.org/profession/pat…
1/3 #GIpath elderly. Sent as "? calculous" found between first and second portion of duodenum. @Histopatolomon @smlungpathguy @yro854 @RunjanChetty @Mvgs1706 @DrMarkOng @DrGeeONE @ariella8 @DanGrahamMD @DrRanasaleh @xenaalabbas @kis_lorand @glinglerimek @Dina_hussein94




Biopsy for CKD and proteinuria. +cryocrit and low C4. IgM dominant GN with MPGN pattern and short microtubules in EM c/w a low grade cyro GN. Organized deposits may be rare and ill formed in cryo GN. EM below is about the best one usually gets. #renalpath #pathtwitter #nephrology




“Small round blue cell tumor “ in a thigh mass; positive for CD99 and NKX2.2 IHCs, what molecular testing can further support the diagnosis🤔 #bstpath #pedipath #surgpath #molecpath #cytogenetics #pathtwitter
How would you describe this architectural pattern, #pathresidents? #PathTwitter



My awesome attending pointed out this incidental sub-urothelial calcification in this RCC case. These are referred to as "Randall's plaques" are thought to be precursors to kidney stones. #PathTwitter #GUPath #urology



#Grosspath #pathresidents #GIpath Cecal appendix #LAMN 1. Evaluate serosa and ink it. 2. Surgical margin. 3. Submit the entire specimen. @DraEosina @luishcruzc @vij_mukul
Eosinophilic sinusitis. Nasal cavity (polyp), excisional biopsy. #pathology #ENTpath




Old cases, day 10: adenovirus appendicitis. This was a pediatric case I found in the archives, so I can’t take credit for the eagle eyes required to spot the viral cytopathic effect (smudgy, glassy nuclei). Never knowingly seen a case since. #pathology #gipath #PathTwitter


United States Trends
- 1. #911onABC N/A
- 2. Fanone N/A
- 3. harry styles N/A
- 4. Jack Smith N/A
- 5. #Aperture N/A
- 6. #BTS_WORLDTOUR N/A
- 7. Minter N/A
- 8. Fable N/A
- 9. #YIAYhouse N/A
- 10. WE BELONG TOGETHER N/A
- 11. Sinners N/A
- 12. jungkook N/A
- 13. Maki N/A
- 14. Massie N/A
- 15. #RavensFlock N/A
- 16. He-Man N/A
- 17. Ivan N/A
- 18. Hanoi Jane N/A
- 19. Happy Anniversary N/A
- 20. Don Davis N/A
You might like
-
 K R
K R
@KathiarRosado -
 M Adib Houreih, M.D, DipRCPath محمد أديب حورية
M Adib Houreih, M.D, DipRCPath محمد أديب حورية
@MAHoureih -
 Nishat Afroz MD
Nishat Afroz MD
@DrNishatAfroz2 -
 tácio.berto
tácio.berto
@tacio_berto -
 Mario Prieto MD PhD
Mario Prieto MD PhD
@dr_MPrieto -
 Marinez Barra
Marinez Barra
@MBizB -
 Silvia Carino
Silvia Carino
@oralpathologyok -
 Severino Rey MD, PhD
Severino Rey MD, PhD
@ReyPathology -
 KS Oh,MD
KS Oh,MD
@KeiShingOh -
 Sfo, MD
Sfo, MD
@forster_ste -
 Salwa Bakhsh
Salwa Bakhsh
@sbakhsh2 -
 Sarra Ben Rejeb
Sarra Ben Rejeb
@SbrSarra
Something went wrong.
Something went wrong.















































































































































